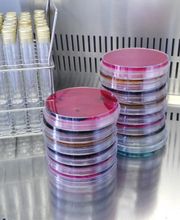
Gallery Cliente
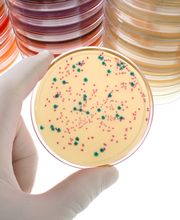
Gallery Cliente

Chiama ora!
Laboratorio Analisi Cliniche Dottori Petraglia
Consulenza aziendale · Ricerca
+393335097789 (Telefono)
+390828724753 (Fax)
Novità e Offerte
Info
Il Laboratorio dei Dottori Petraglia è a Capaccio (SA) in viale della Repubblica 95 A/B. Servizi: analisi del sangue, degli alimenti, delle acque e consulenza. Il Laboratorio Analisi Cliniche Dottori Petraglia, ha iniziato la sua attività nel 1981 con decreto n. 7164 della Regione Campania. Opera come struttura privata fin dalla sua apertura nel campo delle analisi cliniche sviluppando in particolare, come laboratorio generale di base, i settori di CHIMICA CLINICA, EMATOLOGIA ed ELETTROFORESI e come laboratorio specialistico il settore della MICROBIOLOGIA. Tra i servizi offerti dalla struttura possiamo trovare analisi del sangue,test per le intolleranze alimentari, laboratorio di analisi delle sostanze d'abuso, per l'abuso di alcool ecc. Forte di oltre quaranta anni di esperienza, il Laboratorio offre servizi innovativi per la salute, la prevenzione e il benessere dei propri pazienti vantando innumerevoli specializzazioni del suo personale, come biochimica, ematologia, tossicologia, microbiologia e citologia. Dal 1997 il Laboratorio ha esteso il suo campo di interesse attivando una seconda sezione specialistica dedicata al settore AGRO-ALIMENTARE. In particolare effettua indagini microbiologiche e chimico-fisiche su diverse matrici, quali alimenti (latte e derivati, olio, marmellate e confetture, frutta sciroppata, prodotti ittici marinati e sott'olio, molluschi bivalvi vivi, verdure sott'olio, carni fresche e alimenti a base di carne), acque e ambienti di lavoro, per lautocontrollo alimentare (HACCP). Il laboratorio effettua controlli su una notevole quantità di alimenti, tra i quali: latte e derivati, olio, marmellate e confetture, frutta sciroppata, prodotti ittici marinati e sott'olio, molluschi bivalvi vivi, verdure sott' olio, carni fresche e alimenti a base di carne.Cura, inoltre, la predisposizione e la tenuta di manuali di autocontrollo per le industrie alimentari e la formazione del personale addetto alle filiere di lavorazione.
Cash, Check, MasterCard, Visa
Orari di apertura
- Lunedì
- 08:00 a 13:00
- Martedì
- 08:00 a 13:00
- Mercoledì
- 08:00 a 13:00
- Giovedì
- 08:00 a 13:00
- Venerdì
- 08:00 a 13:00
- Sabato
- Chiuso
- Domenica
- Chiuso
Galleria

Mappa
Viale della Repubblica, 95 A/B, 84047 Capaccio Scalo